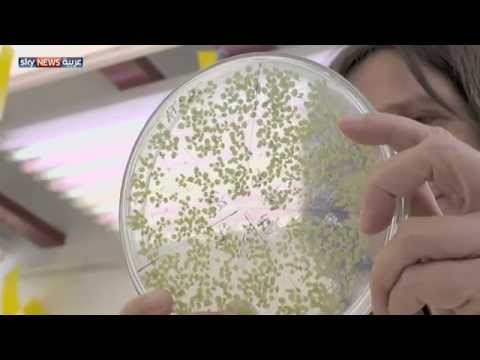
شاهد بدائل للحليب الطبيعي

الرئيسية
أخبارعاجلة
رياضة
- الأخبار الرياضية
- أخبار الرياضة
- فيديو أخبار الرياضة
- نجوم الملاعب
- أخبار الرياضة
- ملاعب عربية وعالمية
- بطولات
- أخبار الأندية العربية
- مقابلات
- رياضة عربية
- رياضة عالمية
- موجب
- سالب
- مباريات ونتائج
- كرة الطائرة
- كرة اليد
- كرة السلة
- رمي
- قفز
- الجري
- تنس
- سيارات
- غولف
- سباق الخيل
- مصارعة
- جمباز
- أخبار المنتخبات
- تحقيقات
- مدونات
- أخبار المحترفين
- غاليري
ثقافة
إقتصاد
فن وموسيقى
أزياء
صحة وتغذية
سياحة وسفر
ديكور